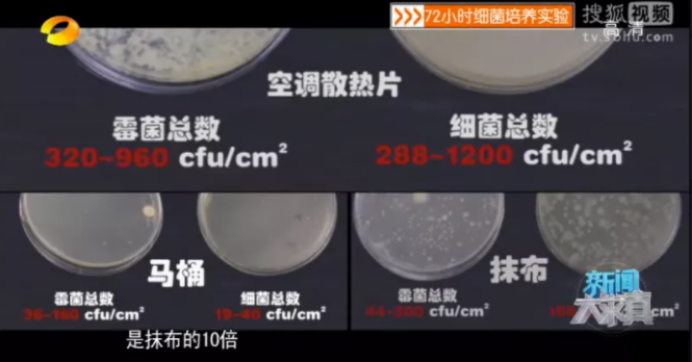

最近天气热,都吹上空调了吧?
那我给你们讲个故事:
从前有一个人,开空调吹着吹着,吹出了“面瘫”!

紧张不?
再给你们讲个故事:
从前有一个人,开空调吹着吹着,住进了ICU抢救!

震惊不?
开空调是为了“续命”,咋变“夺命”了?


问你一个问题:你家空调几年没洗了?
知道现在它多脏了么?


确实,很多人可能已经知道“空调滤网”要拆下来洗。
但你知道,空调滤网后面的“散热片”,才是真正的重灾区吗?!

“散热片”是交换冷热空气用的,所以空气里的灰尘、细菌就很容易钻进去,在它上面越积越厚。

而它又不像空调滤网一样能拆下来洗,因此很多人都忽视了!

中国疾控中心曾做过调查,国内88%的空调散热片细菌总数超标。
一块没洗过的空调散热片,细菌含量是马桶的60倍,抹布的10倍!
在散热片的“努力”下,只需72小时,就能吹霉一碗米饭……

只需120小时,就能吹霉一块玻璃……

你想想这样的空调风吹在你身上,可不得出事吗!
如果你吹着吹着高烧了,可能就是“金黄色葡萄球菌”“链球菌”惹的祸。
更可怕的是,散热片里还藏着一种致命的“军团菌”。
军团菌可以在20℃-42℃环境里生长,而散热片工作时会产生潮湿水汽,又是这种菌特别爱的环境。

一旦吸入军团菌,就有可能感染“军团菌肺炎”,引起急性呼吸衰竭。
不好好治疗的话,这玩意儿致死率能高达30%!

开头那个不幸住进ICU的老哥,就是被“军团菌”害的。

这种事还不是个例:
长沙一个小伙突发高烧、呼吸困难,去医院一查,也是空调惹的祸。

真的很危险!请务必注意!



夏天从热爆的室外进空调房,把满是汗的脸凑近空调吹,特别爽!
你是不是这么干过?可别再这样了!

面部血管在一热一冷的刺激下,可能会收缩痉挛,产生供血障碍,导致脸上神经功能受损。
于是你就会“眼斜嘴歪”“面部麻痹”,出现传说中的——“面瘫”。

年年夏天都有相当多吹空调面瘫的人,而且这病不挑年龄……




如果你本身有三高、心脏病,开空调更要注意了!
苏州的胡先生半夜突然胸痛、恶心呕吐,送去医院一查,“下壁心肌梗死”,吹空调温度太低诱发的。

医生解释,“冷”会让交感神经兴奋,血管急剧收缩,容易形成血栓。
身体不好的人,就有可能会急性心肌梗死!


大家应该都有体验,空调房里呆久了,觉得眼睛涩涩的、咽喉痛痛的。
因为空调房真的很干!

室内空气湿度过低,就会导致眼结膜干涩,增加得“干眼症”的概率。
鼻黏膜干燥,还容易流鼻血、咽喉炎……
说到这,吹空调的危险已经尽数体现。


先别急着吹,好久没用空调前,里里外外都给洗刷一遍!
除了请专业人员洗,自己在家也可以:

开空调吹的时候也要注意!

想要防止空调房里干燥?
可以选择放一盆水、湿拖把拖地、用加湿器,测试显示都有效!

最后,还有一点希望大家注意:
空调清洗邻团拼福利活动(5人团,限时抢购)
 49元/台,等您参团!
49元/台,等您参团!
挂机空调高温消毒杀菌
2台98 3台147
4台196 5台245
6台294 7台343
流程化操作、周边环境防护
使用160℃高温蒸汽机高温高压清洗.杀菌,消毒,除异味。
限花都区抢先订,早买早约不排队!现在下单成团后即可预约~


已同步到看一看
写下你的想法